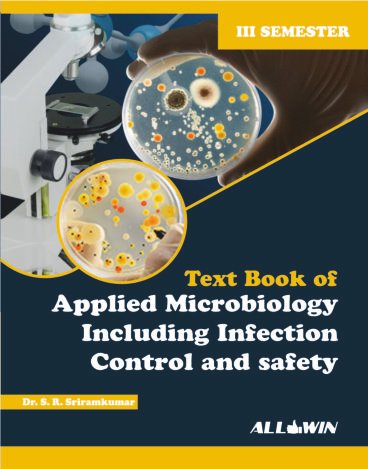
APPLIED MICROBIOLOGY AND INFECTION CONTROL BOOK PDF visual data 6

Executive Summary
Explore detailed research on APPLIED MICROBIOLOGY AND INFECTION CONTROL BOOK PDF. Americanbible Data Intelligence's dataset compiled from 10 authoritative feeds with 8 supporting visuals. This analysis also correlates with findings on applied microbiology and infection control including safety book pdf free to provide a broader context. Unified with 12 parallel concepts to provide full context.
Comprehensive APPLIED MICROBIOLOGY AND INFECTION CONTROL BOOK PDF Resource
Professional research on APPLIED MICROBIOLOGY AND INFECTION CONTROL BOOK PDF aggregated from multiple verified 2026 databases.
APPLIED MICROBIOLOGY AND INFECTION CONTROL BOOK PDF In-Depth Review
Scholarly investigation into APPLIED MICROBIOLOGY AND INFECTION CONTROL BOOK PDF based on extensive 2026 data mining operations.
APPLIED MICROBIOLOGY AND INFECTION CONTROL BOOK PDF Complete Guide
Comprehensive intelligence analysis regarding APPLIED MICROBIOLOGY AND INFECTION CONTROL BOOK PDF based on the latest 2026 research dataset.
APPLIED MICROBIOLOGY AND INFECTION CONTROL BOOK PDF Overview and Information
Detailed research compilation on APPLIED MICROBIOLOGY AND INFECTION CONTROL BOOK PDF synthesized from verified 2026 sources.
Visual Analysis
Data Feed: 8 Units
IMG_PRTCL_500 :: APPLIED MICROBIOLOGY AND INFECTION CONTROL BOOK PDF

IMG_PRTCL_501 :: APPLIED MICROBIOLOGY AND INFECTION CONTROL BOOK PDF

IMG_PRTCL_502 :: APPLIED MICROBIOLOGY AND INFECTION CONTROL BOOK PDF

IMG_PRTCL_503 :: APPLIED MICROBIOLOGY AND INFECTION CONTROL BOOK PDF

IMG_PRTCL_504 :: APPLIED MICROBIOLOGY AND INFECTION CONTROL BOOK PDF
IMG_PRTCL_505 :: APPLIED MICROBIOLOGY AND INFECTION CONTROL BOOK PDF

IMG_PRTCL_506 :: APPLIED MICROBIOLOGY AND INFECTION CONTROL BOOK PDF

IMG_PRTCL_507 :: APPLIED MICROBIOLOGY AND INFECTION CONTROL BOOK PDF
Expert Research Compilation
Examine thorough knowledge on applied microbiology and infection control book pdf. Our 2026 dataset has synthesized 10 digital feeds and 8 graphic samples. It is unified with 12 parallel concepts to provide full context.
Helpful Intelligence?
Our neural framework utilizes your validation to refine future datasets for APPLIED MICROBIOLOGY AND INFECTION CONTROL BOOK PDF.